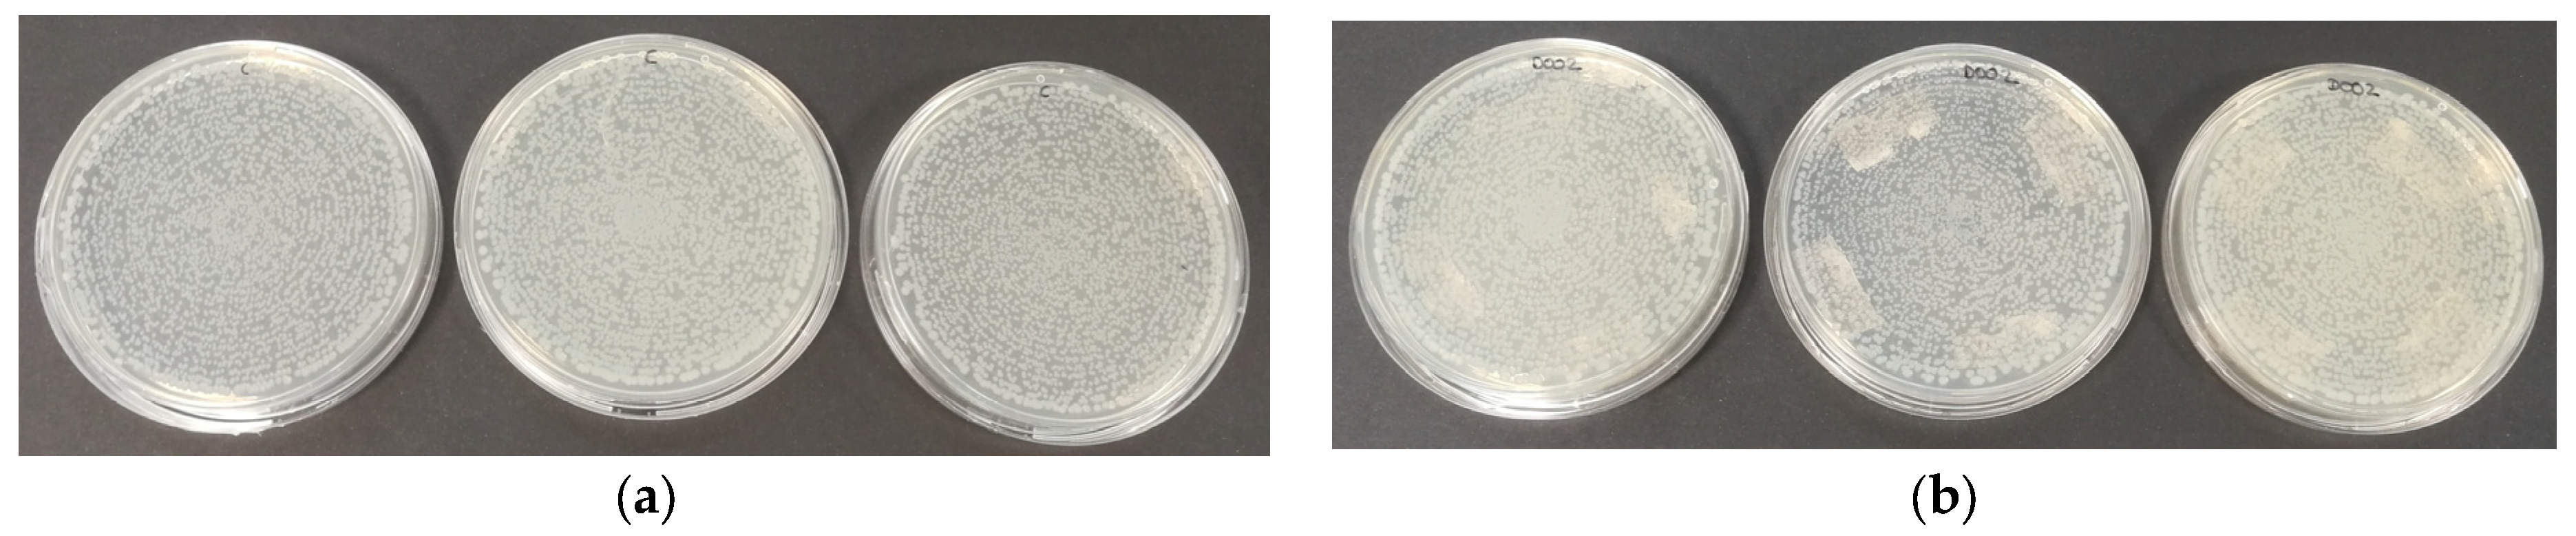
Polymers 16 01245 g006
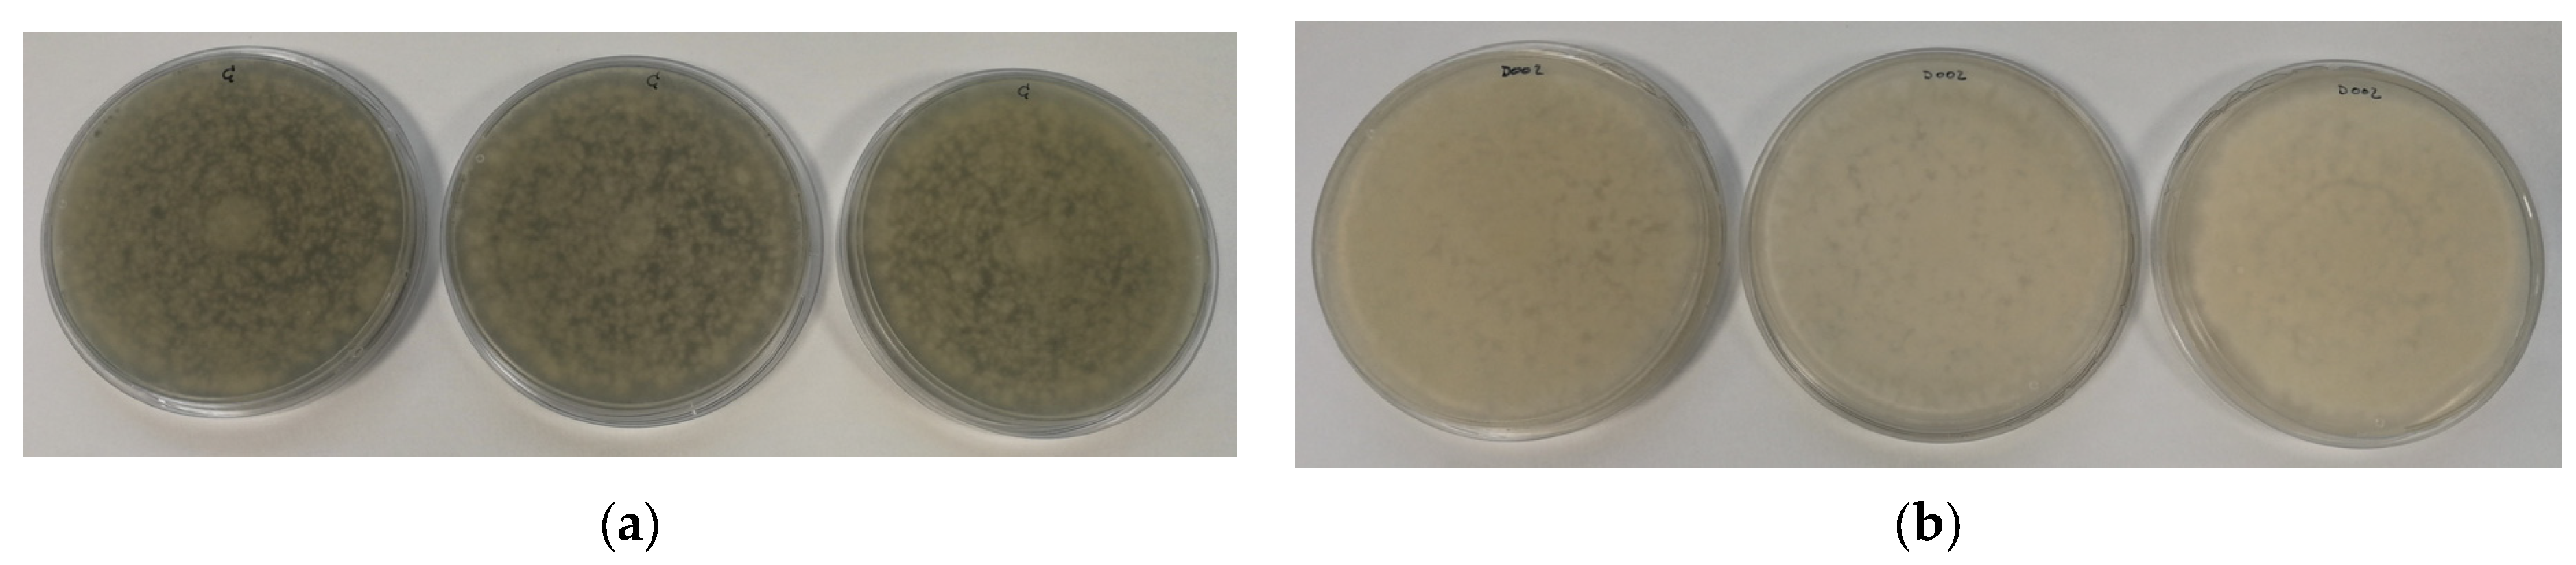
Polymers 16 01245 g009
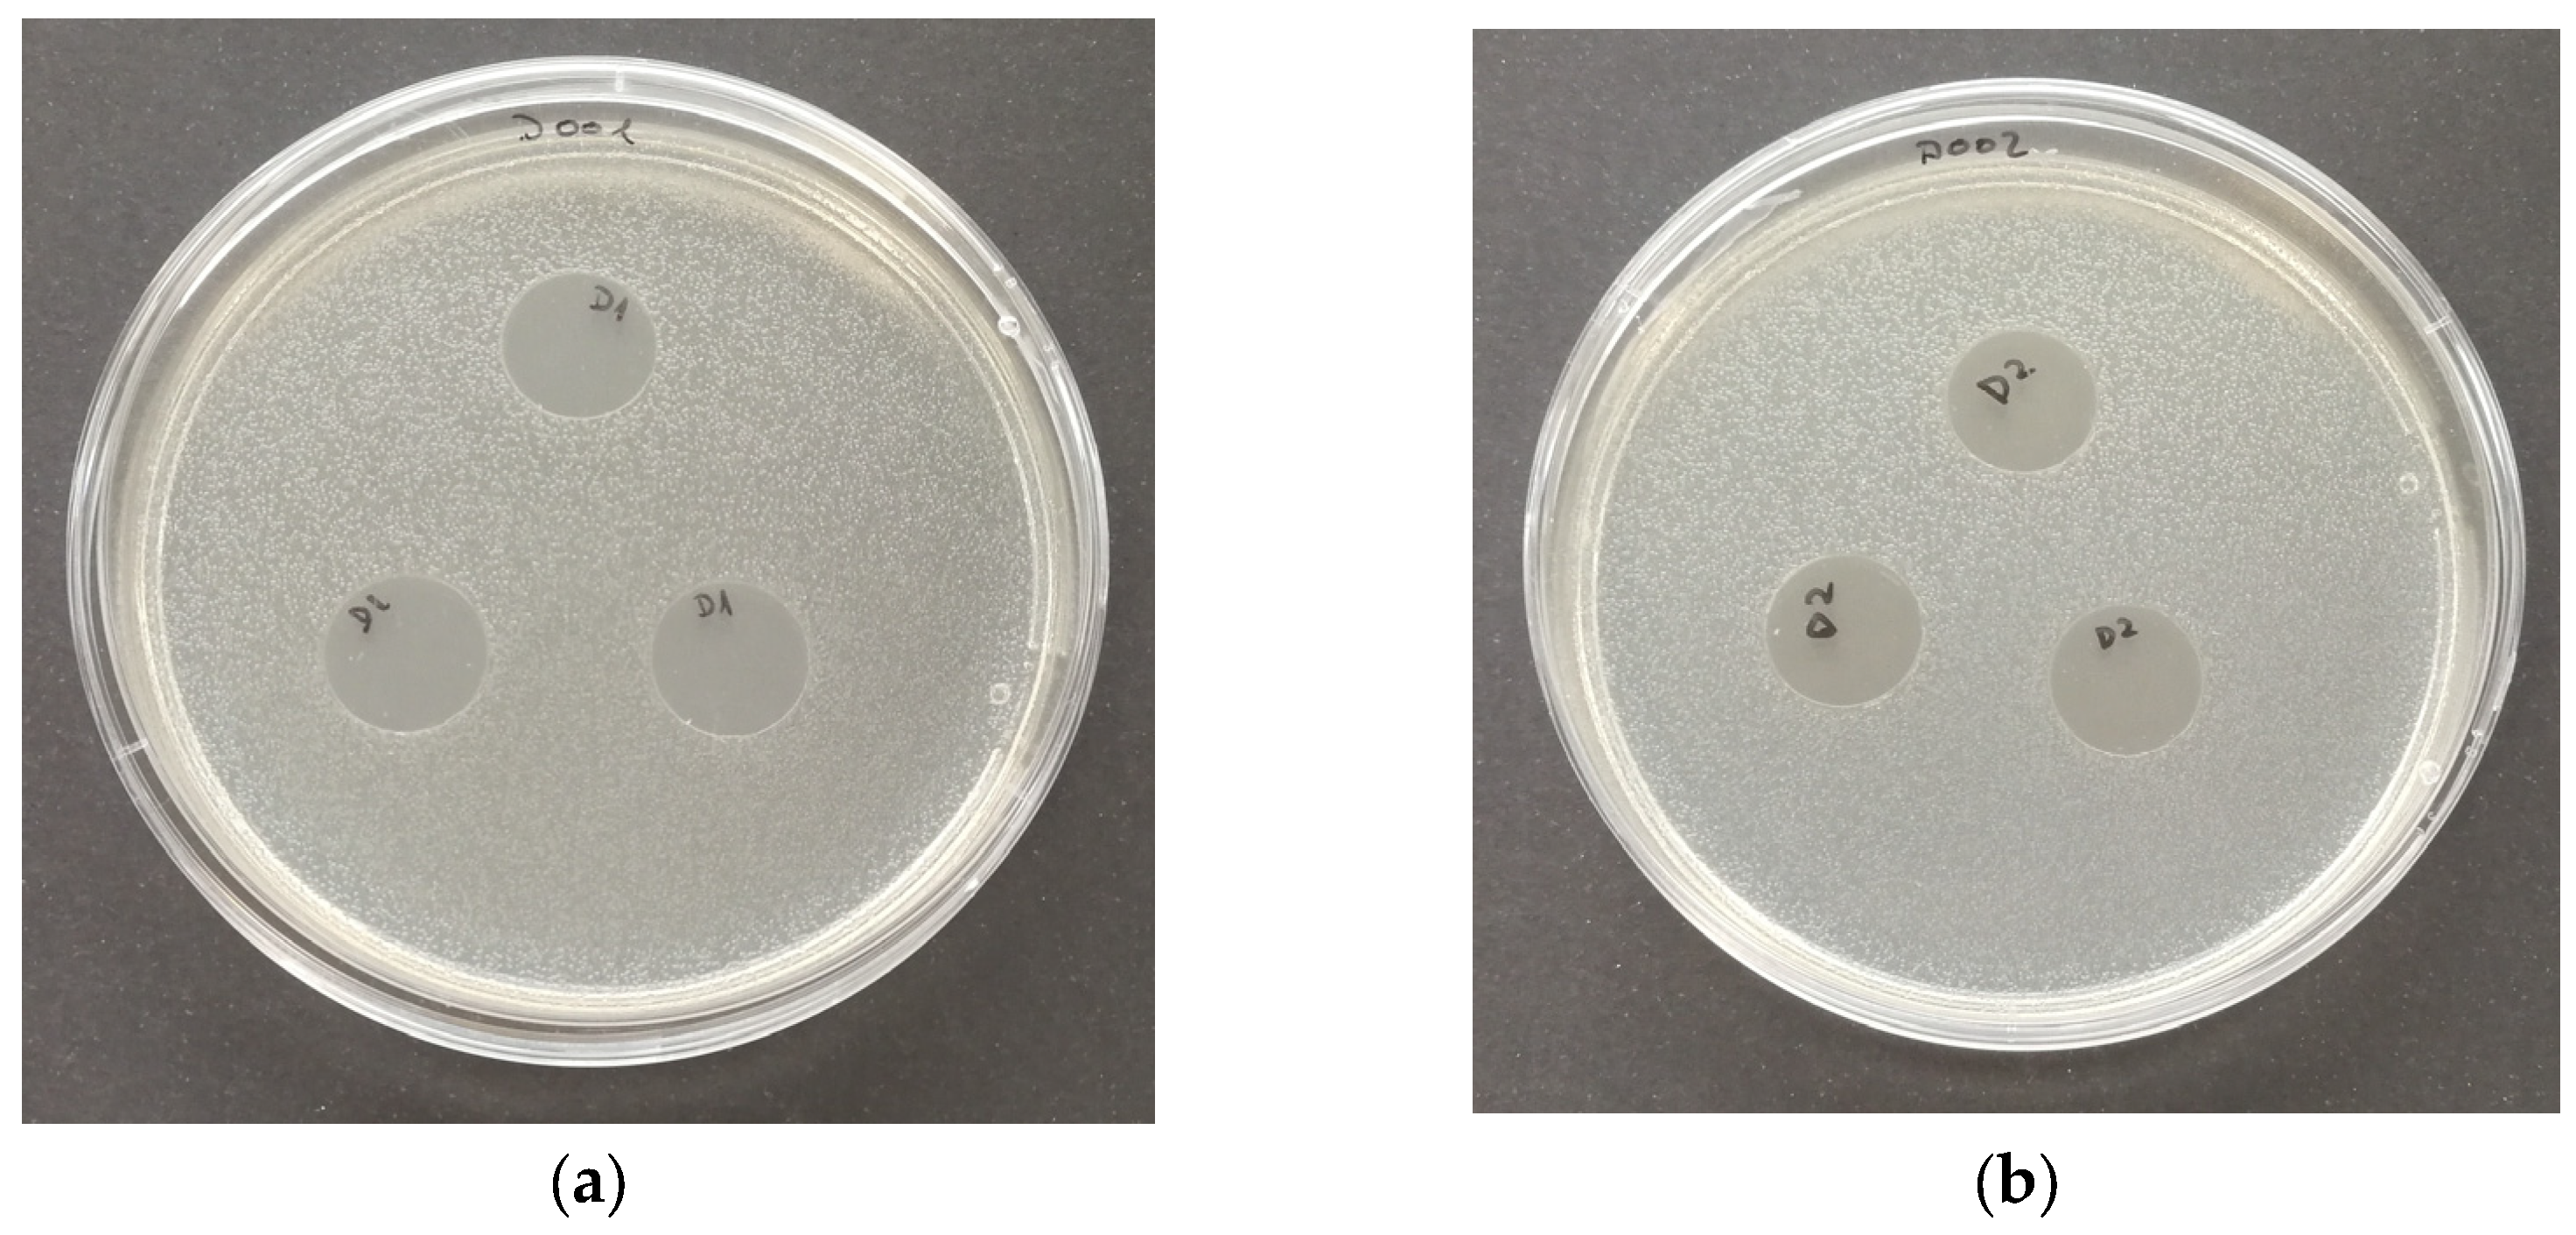
Polymers 16 01245 g010
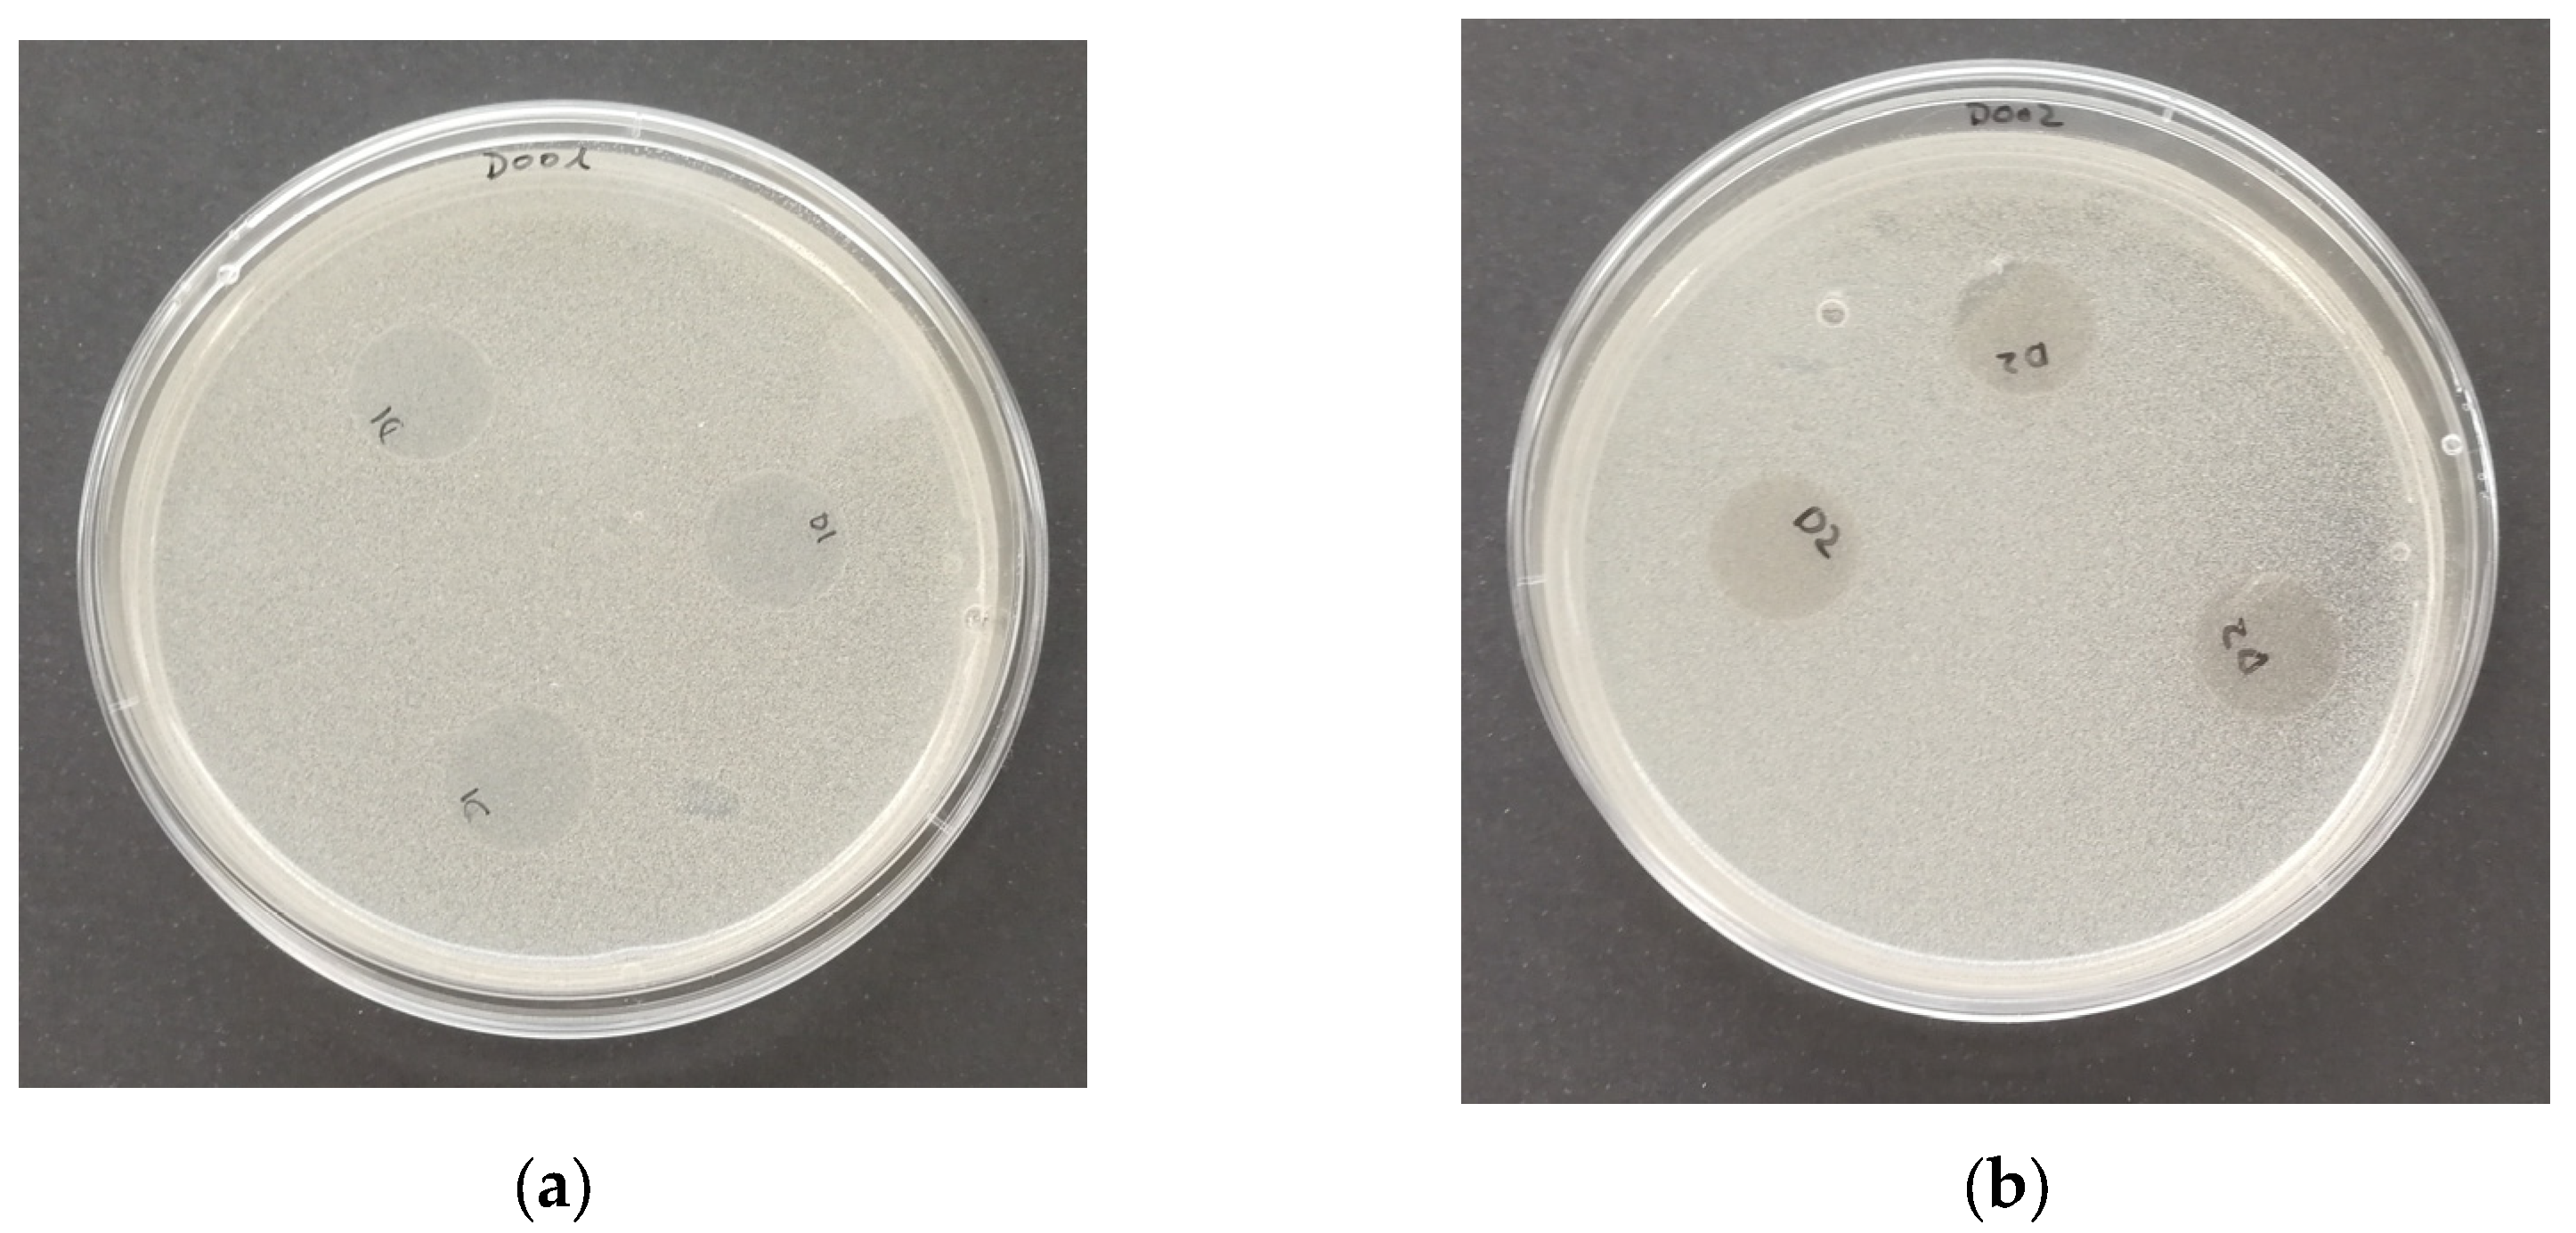
Polymers 16 01245 g012

3.4. Mechanical Properties
Table 4 and
Table 5 show the results obtained in the tensile test in the longitudinal and cross-direction, respectively. The main statistically significant differences found were related to the polymer itself. In this sense, when force was applied in both directions, the same tendency was observed; in general, PLA-based films presented higher Young’s modulus values than PP-based films, which means that they were stiffer. On the other hand, values of the elongation at break parameter were found to be about two orders of magnitude higher for PP-based films than those for PLA-based films, resulting in films that were more deformable and less brittle than PLA-based films, in line with the values obtained for Young’s modulus.
Regarding tensile strength, values of the same order were found for both types of films, although they were slightly higher for PLA-based films, which means that a higher force must be applied to deform PLA-based films compared with that required for PP-based films. In conclusion, when PP is used as the base polymer, more deformable and more flexible films are obtained than when PLA is used.
Finally, when analyzing the effect of the incorporation of active substances into the different polymeric matrices, the mechanical properties of PP were affected by the incorporation of OPE, as can be seen in the significant increase in the elongation at break and tensile strength parameters in the cross-direction test. This fact could be due to the composition of OPE, which is rich in phenolic compounds and flavonoids, which make films more deformable. This trend aligns with the results obtained by Antosik et al. (2021) [
37] when incorporating green tea extract and oregano oil PP cast films. The presence of terpenes in the extract can act as a plasticizer, which can weaken the intermolecular forces between the polymeric chains, allowing an increase in elongation at break.
However, the mechanical properties evaluated in the longitudinal direction of the films developed in this study, based on PP and PLA, were modified by the incorporation of OPE.
3.5. Sealability
Table 6 shows the values of the sealing parameters and the sealing strength of the evaluated films.
Figure 3 shows the force vs. elongation plots of the films once their inner side was sealed. The sealing parameters are the combination of the temperature, pressure, and time needed to seal the film on the inner side, which is the food contact side. This test simulates the actual use of the film, conceived to make bags for fruits and vegetables, and allows us to evaluate if it is possible to manufacture the bags, since they will need to be sealed on their internal side (the food contact side). The test also allows us to evaluate the sealing strength of the seal, and therefore, whether or not the bags will withstand the weight of the packaged product without breaking at the sealing area, during transportation, storage, and opening [
38].
As it can be observed, all the tested films were sealable, so bags can be made with all the references developed. No differences in the sealing parameters were observed due to the presence of the active substance, OPE. However, concerning the polymer, films based on PLA needed higher pression and a longer sealing time to be sealed than PP based films. Regarding sealing strength, this parameter abruptly increased when OPE was incorporated into the PP films. The opposite tendency was observed when using PLA as polymeric matrix. In this latter case, sealing strength was found to be significantly lower for the film containing OPE. In this sense, when OPE is incorporated into PP, structural changes occur in the polymer, perhaps due to the movement of chains, which become more available and allow stronger bonding between PP sheets, which, once sealed, are more costly to separate compared with those made with polymers without OPE. This is reflected in the higher value of the “sealing strength” parameter in the film containing OPE compared with that of the control without the active ingredient.
In any case, the results obtained show strong sealing, and the possibility of forming bags, which are expected to be suitable for fruits and vegetables from a mechanical point of view.
3.6. Thermal Characterization
The thermogram curves of the bilayer films with and without OPE in the PP and PLA matrixes are shown in
Figure 4. The thermal parameters, T
dmax, T
onset, and residue, were analyzed and are reported in
Table 7. As can be observed in the cited figure and tables, the PP bilayer decomposed in a single step, T
max was registered to be 383 ± 3 °C, and T
onset was at 365 ± 4 °C. When adding OPE to the polymer formulation, these parameters did not present variations, as the T
max registered was 383 ± 2 °C and the T
onset registered was 365 ± 3 °C. On the other hand, no residue was registered at the end of the trial.
It is well known that antioxidant compounds can increase the free volume of the polymer matrix by acting as pseudo plasticizers, and as a result, the incorporation of certain amounts of these active compounds could change the polymer’s thermal properties [
39] (Lopez-Rubio and Lagaron, 2011). Nevertheless, in this study, the incorporation of OPE did not affect the thermal properties of PP, which is considered to be a positive effect as it does not significantly alter the thermal stability of the polymer. On the other hand, it could also be that OPE partially separates from the polymer phase and recrystallizes on the surface [
40]. However, the other properties studied were not affected, so if this were to occur, it would not have a significant impact on the other properties of the materials obtained.
The PLA bilayer also decomposes in a single-step process with a Tmax and Tonset of 330 °C; however, when adding OPE, the Tonset and Tmax values decrease to 292 ± 1 °C and 302 ± 1 °C, respectively. Thus, the results obtained show that the incorporation of OPE slightly decreased the thermal stability of the PLA bilayer film. However, although there is an impact after OPE incorporation, it is not possible to quantify the extract present in the material, as it may have been degraded or lost during processing.
The calorimetric curves obtained during the heating of the samples are shown in
Figure 5. The thermal parameters of the films are listed in
Table 8. The PP samples exhibited a melting peak around 142 °C. A displacement of the DSC curve around 50 °C was also observed, probably due to the temperature dependence of the PP crystalline structure, while in the PLA sample curves, three different transitions could be observed: a glass transition, cold crystallization, and melting. Both PLA and PLA + OPE showed cold crystallization and melting at approximately 114 °C and 150 °C, respectively, indicating that OPE did not modify the mobility of the polymer chains. The extracts did not influence the thermal properties of the films in the studied temperature range, since only polymer transitions were observed.
3.9. Food Safety Assessment
Migration tests
Table 9 shows a summary of the results obtained in the overall migration test carried out on the active packaging prototypes. The results are expressed as the average value ± the uncertainty of the method, for each of the analyzed simulants. As can be seen, all the overall migration values obtained are lower than the established limit of 10 mg/dm
2, so all the prototypes are compliant. In this sense, based on the overall migration test result alone, the films would be suitable for contact with fresh fruits and vegetables as well as washed and cut (ready to eat) fruits and vegetables during prolonged storage at room temperature or below, including packaging under hot-fill conditions and/or heating up to a temperature, T, of 70 °C ≤ T ≤ 100 °C for a maximum of t = 120/2 ^ [(T − 70)/10] minutes.
On the other hand, the results of the specific migration of the different substances analyzed are shown in the following tables.
Table 10 presents the specific migration results for primary aromatic amines, whereas
Table 11 shows the results of the specific migration of metals included in Annex II of the Plastics Regulation. The results are expressed as the average value ± uncertainty of the method, for each of the analyzed simulants.
As far as compliance with the restrictions laid down in Annex II of the Plastics Regulation for primary aromatic amines is concerned, all the references are compliant, as the specific migration of each one of these compounds is, in all cases, below the detection limit, and so it is below the migration limit established for these substances individually in 2 ppb.
Regarding metals, the specific migration of the metals analyzed are in acordance with the limits set out by legislation in all the references, most of them even being below their limit of quantification.
In this respect, if compliance is only be based on this analysis, the films would be suitable for contact with fresh fruits and vegetables as well as washed and cut (ready to eat) fruits and vegetables for a maximum of 30 days at temperatures up to 40 °C. These conditions include the foreseeable use of the films.
Screening of NIAS
The substances identified in the different fractions are presented in the following tables.
Table 12 shows the list of substances in the volatile fraction. No substances were found for this fraction of compounds coming from the reference, PP + OPE.
Table 13 displays the list of compounds identified in the semi-volatile fraction of the NIAS. Semi-volatile substances were only identified in the PP reference in simulant A and in the PLA reference in both simulants A and B. Finally, in
Table 14, results of the screening analysis of the non-volatile fraction of NIAS are shown.
In the screening of the different fractions of NIAS, in the case of the PP film sample, four substances in total were detected, from which ethanol and triacetin were detected in the volatile fraction, while one semi-volatile substance (2-fluoroacetamide) and one non-volatile substance, which was galactitol, were detected.
When adding OPE into the PP matrix, no volatile or semi-volatile substances were detected, but five non-volatile substances were identified. The incorporation of OPE resulted in the release of substances clearly coming from OPE like ethylvanillin. Other substances such as Cyasorb 2908, bisphenol A, and methylparaben may come from additives and impurities in raw materials; however, they were not detected in the PP film. This could be due to the fact that the incorporation of OPE could have opened up the chains of the polymer, facilitating the mobility of the molecules and their diffusion through the PP matrix into the migrating extract.
On the other hand, from PLA film, substances from polymer degradation, residues of monomers, and starting substances, as well as impurities that came with the raw materials used in the processing of PLA-based films were found. In this sense, five volatile substances (triacetin, 2-hydroxyethylhydrazine, allyl acetate, acetic anhydride, and lactide), one semi-volatile substance (sulfur dichloride), and six non-volatile substances, 2,7-dichlorofluorescin diacetate, 2-amino-4-methylbenzophenone, 3,3′-diclorobenzidine, epigallocatechin gallate, triglycerol, and 6-hydroxycaproic acid, were detected.
On the other hand, from PLA + OPE film, in total, 14 volatile substances, 2-hydroxyethylhydrazine, acetic anhydride, lactide, diacetyl suplhide, acetic acid, 2,3-butanedione, 2,3-pentanedione, cyclobutylamine, (R,R)-3-Chloro-2-butanol, [S-(R,R)]-2,3-butanediol, 2-hydroxy-3-pentanone, isobutane, 4-oxo-pentanoci acid, and ethyl pyruvate, and 13 non-volatile substances, ethylvanillin, methylparaben, 2,7-dichlorofluorescin diacetate, 3,3′-dichlorobenzidine, epigallocatechin gallate, triglycerol, 6-hydroxycaproic acid, Cyasorb UV 12, naringin, succinic acid, adipic acid, and trans-ferulic acid, were detected. Furthermore, the presence of compounds such as ethylvanillin and naringin indicated the incorporation of OPE into the PLA matrix.